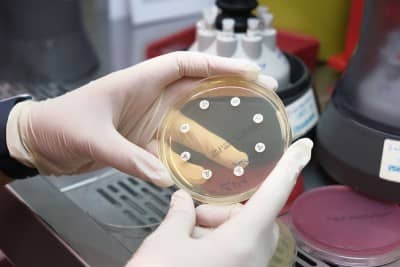
Ekim (İnokülasyon) - 4

NPİSTANBUL Hastanesi Mikrobiyoloji Laboratuvarında, klinik hekimlerin isteği doğrultusunda yapılan testler büyük bir titizlikle ve uluslararası kabul görmüş yöntemlerle, kabul edilebilir hata sınırları içerisinde çalışılmaktadır. Bu anlayışımız çerçevesinde tanı, takip, risk ve prognoz belirlemeye yönelik laboratuvar hizmetlerimiz, ekip çalışması ile hasta odaklı olarak devam ettirilmektedir.
İçindekiler
NPİSTANBUL Hastanesi Mikrobiyoloji Laboratuvarı olarak hedefimiz, teknolojik ve bilimsel gelişmeler ışığında test panelimizi genişleterek, eğitimli ve nitelikli kadromuzla hizmet kalitemizi artırmaktır.
Mikrobiyoloji Laboratuvarı Nedir?
Mikrobiyoloji laboratuvarı, mikroorganizmaların (bakteriler, virüsler, mantarlar ve parazitler) tanımlanması, incelenmesi ve teşhis edilmesi için kullanılan bir tıbbi laboratuvardır. Bu laboratuvarlar, hastalıkların tanı ve tedavisinde kritik bir rol oynar. Mikrobiyoloji laboratuvarında yapılan testler, enfeksiyonların kaynağını belirlemeye, uygun tedavi yöntemlerini seçmeye ve halk sağlığını korumaya yardımcı olur.
Bakteriyoloji Testleri
Bakteriyoloji, bakterilerin incelenmesi ve tanımlanması ile ilgilenir. Bu alanda yapılan testler şunlardır:
Boğaz Kültürü: Boğaz enfeksiyonlarının nedenini belirlemek için kullanılır.
İdrar Kültürü: İdrar yolu enfeksiyonlarının teşhisinde kullanılır.
Gaita Kültürü: Sindirim sistemi enfeksiyonlarının tanısında kullanılır.
Yara Kültürü: Yara enfeksiyonlarının sebebini belirlemek için kullanılır.
Balgam Kültürü: Solunum yolu enfeksiyonlarının teşhisinde kullanılır.
Vajen Serviks Kültürü: Jinekolojik enfeksiyonların tanısında kullanılır.
Burun Kültürü: Burun enfeksiyonlarının teşhisinde kullanılır.
Meni Kültürü: Üreme organları enfeksiyonlarının tanısında kullanılır.
Konjunktiva Kültürü: Göz enfeksiyonlarının tanısında kullanılır.
Bakteri Tanımlanması ve Duyarlılık Testi: Bakterilerin tanımlanması ve hangi antibiyotiklere duyarlı olduklarının belirlenmesi için kullanılır.
Beyin Omurilik Sıvısı (BOS) Kültürü: Merkezi sinir sistemi enfeksiyonlarının tanısında kullanılır.
Boyalı Mikroskopik İnceleme (Gram, Metilen Mavisi, Wright, EZN): Bakterilerin boyanarak mikroskop altında incelenmesi için kullanılır.
Kan Kültürü: Kan dolaşımındaki enfeksiyonların teşhisinde kullanılır.
Kateter Kültürü: Kateter enfeksiyonlarının tanısında kullanılır.
Mycoplasma Kültürü: Mycoplasma türü bakterilerin teşhisinde kullanılır.
Periton Kültürü: Karın boşluğundaki enfeksiyonların tanısında kullanılır.
Plevral Kültürü: Akciğer zarındaki enfeksiyonların tanısında kullanılır.
Mikoloji Testleri
Mikoloji, mantarların incelenmesi ile ilgilenir. Bu alanda yapılan testler şunlardır:
Deri ve Mukozada Mantar Aranması (KOH): Deri ve mukozadaki mantar enfeksiyonlarının teşhisinde kullanılır.
Mantar Kültürü: Mantar enfeksiyonlarının tanısında kullanılır.
Mantar Tanımlanması ve Antifungal Duyarlılık Testi: Mantarların tanımlanması ve hangi antifungal ilaçlara duyarlı olduklarının belirlenmesi için kullanılır.
Moleküler Mikrobiyoloji Testleri
Moleküler mikrobiyoloji, mikroorganizmaların genetik materyalinin incelenmesi ile ilgilenir. Bu alanda yapılan testler şunlardır:
HBV-DNA Kantitatif: Hepatit B virüsünün DNA miktarını ölçer.
HCV-RNA Kantitatif: Hepatit C virüsünün RNA miktarını ölçer.
HDV-RNA Kantitatif: Hepatit D virüsünün RNA miktarını ölçer.
Covid-19 (SARS-CoV-2) PCR Testi: Covid-19 virüsünün varlığını doğrulamak için kullanılır.
Parazitoloji Testleri
Parazitoloji, parazitlerin incelenmesi ile ilgilenir. Bu alanda yapılan testler şunlardır:
Gaitada Direkt Parazit İnceleme: Bağırsak parazitlerinin teşhisinde kullanılır.
Plasmodium Aranması: Sıtma parazitlerinin teşhisinde kullanılır.
Oksiyur Aranması Selofan Bant (Anal): Bağırsak kurtlarının teşhisinde kullanılır.
Gaitada Amip-Giardia Aranması: Amip ve giardia parazitlerinin teşhisinde kullanılır.
Seroloji Testleri
Seroloji, kan serumunda antikorların incelenmesi ile ilgilenir. Bu alanda yapılan testler şunlardır:
Anti HAV IgG ve Anti HAV IgM: Hepatit A (sarılık) virüsüne karşı oluşan antikorların tespiti için kullanılan testlerdir.
HBsAg, HBeAg, Anti HBc IgG, Anti HBc IgM, Anti HBe, Anti HBs: Hepatit B (sarılık) hastalığının tanısı, ilerlemesi ve taşıyıcılığın takibinde kullanılan testlerdir
HCV, Anti HCV: Hepatit C hastalığının tanısı ve taşıyıcılığın takibinde kullanılan testlerdir.
Anti Rubella IgG ve IgM: Kızamıkçık virüsüne karşı oluşan antikorların tespiti.
Anti Toksoplazma IgG ve IgM: Toksoplazma enfeksiyonuna karşı oluşan antikorların tespiti.
Borrelia burgdorferii IgG ve IgM: Lyme hastalığına neden olan Borrelia burgdorferii bakterisine karşı oluşan antikorların tespiti.
Brucella Aglütinasyon Testi (Rose Bengal) ve Brucella Tüp Aglütinasyonu: Brucella (malta humması) enfeksiyonlarının teşhisinde kullanılır.
Chlamydia trachomatis IgG: Chlamydia enfeksiyonlarının teşhisinde kullanılır.
Leptospira IgG ve Leptospira IgM: Leptospirozis enfeksiyonlarının teşhisinde kullanılır.
Clostridium difficile Toxin A ve B: Clostridium difficile enfeksiyonlarının teşhisinde kullanılır.
CMV IgG Avidite: Sitomegalovirüs enfeksiyonlarının tanısı ve zamanı hakkında bilgi verir.
Delta Antikoru: Hepatit D virüsüne karşı oluşan antikorların tespiti.
EBV VCA IgG ve IgM: Epstein-Barr virüsü enfeksiyonlarının teşhisinde kullanılır.
Helicobacter Pylori IgG ve Antijen: Helicobacter pylori enfeksiyonlarının teşhisinde kullanılır.
Herpes Simpleks Tip 1 ve Tip 2 IgG ve IgM: Herpes simpleks virüsü enfeksiyonlarının teşhisinde kullanılır.
HIV Doğrulama (Western-Blot): HIV enfeksiyonlarının kesin teşhisinde kullanılır.
Kabakulak IgG ve IgM: Kabakulak enfeksiyonlarının teşhisinde kullanılır.
Kızamık IgG ve IgM: Kızamık enfeksiyonlarının teşhisinde kullanılır.
Kist Hidatik İHA: Kist hidatik hastalığının teşhisinde kullanılır.
Mycoplasma Pneumoniae IgG ve IgM: Mycoplasma pneumoniae enfeksiyonlarının teşhisinde kullanılır.
Parvovirus B19 IgG ve IgM: Parvovirus B19 enfeksiyonlarının teşhisinde kullanılır.
Rotavirus Antijeni: Rotavirüs enfeksiyonlarının teşhisinde kullanılır.
Rubella IgG Avidite: Kızamıkçık enfeksiyonlarının teşhisinde kullanılır.
Salmonella Tüp Aglütinasyonu (Gruber-Widal): Salmonella enfeksiyonlarının (Tifo, Paratifo) teşhisinde kullanılır.
Toxoplasma IgG Avidite: Toksoplazma enfeksiyonlarının teşhisinde kullanılır.
Treponema Pallidum Hemaglütinasyon (TPHA), Sifilis IgG: Sifiliz (frengi) enfeksiyonlarının teşhisinde kullanılır.
Varicella zoster Virus (VZV) IgG ve IgM: Suçiçeği ve zona enfeksiyonlarının teşhisinde kullanılır.
Covid-19 (SARS-CoV-2) Hızlı Antijen Testi: Covid-19 virüsünün hızlı teşhisinde kullanılır.
Mikrobiyoloji laboratuvarı, çeşitli enfeksiyon hastalıklarının tanısında kritik bir rol oynar. Bakteriyoloji, mikoloji, moleküler mikrobiyoloji, parazitoloji ve seroloji gibi çeşitli testler sayesinde, hastalıkların kaynağı hızlı ve doğru bir şekilde belirlenebilir. Bu laboratuvarlar, tedavi planlaması ve halk sağlığının korunmasında büyük önem taşır.